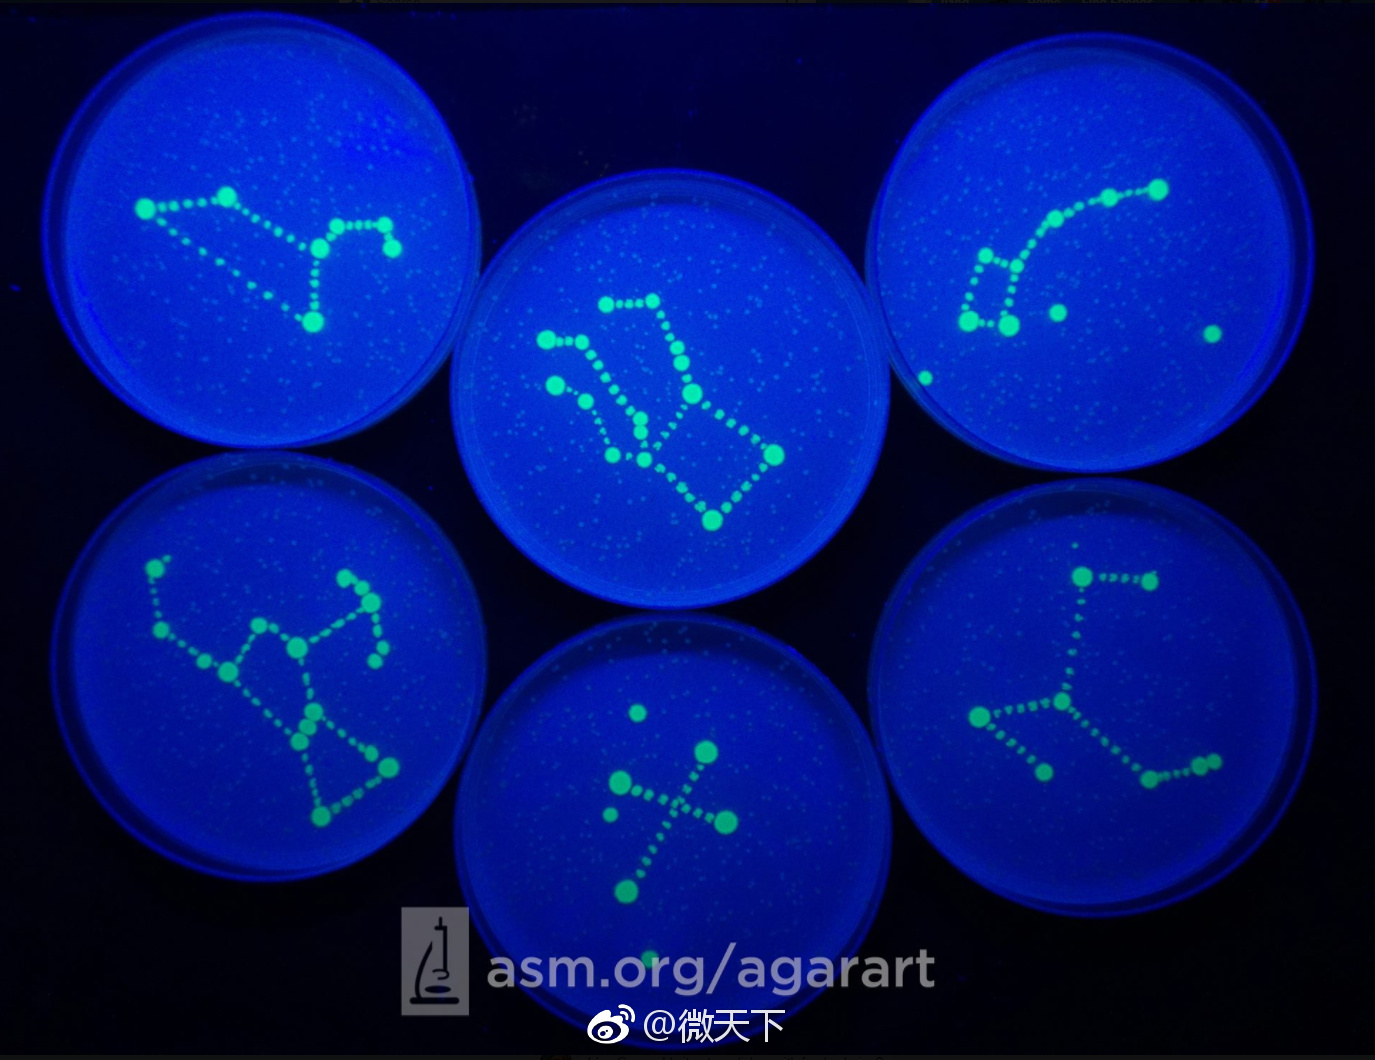
你在纸上画画还不行人家已经拿培养基画画了

培养基作画

用培养基为画布不同颜色的菌种作为画笔画出的艺术画,太特别太致命啦!
图片尺寸640x671
绘画大赛公布了比赛结果美国微生物学会2018年培养基作画就是如此神奇
图片尺寸1064x1052
美国微生物学会的培养皿绘画大赛.【多图】
图片尺寸690x515
科学的浪漫第一届培养基微生物作画大赛作品展示
图片尺寸670x679
生物学霸们用培养基作画
图片尺寸420x414
你在纸上画画还不行人家已经拿培养基画画了
图片尺寸1375x1060
我在纸上画画还不行人家已经拿培养基画画啦
图片尺寸690x690
科学的浪漫第一届培养基微生物作画大赛作品展示
图片尺寸833x835
我在纸上画画还不行人家已经拿培养基画画啦
图片尺寸818x936
我在纸上画画还不行人家已经拿培养基画画啦
图片尺寸554x544
我在纸上画画还不行人家已经拿培养基画画啦
图片尺寸690x666
科学的浪漫第一届培养基微生物作画大赛作品展示
图片尺寸848x846
我在纸上画画还不行人家已经拿培养基画画啦
图片尺寸1052x1053
科学家们的艺术:培养皿里种出"画"
图片尺寸600x748
你在纸上画画还不行人家已经拿培养基画画了
图片尺寸993x1048
以细菌为笔,在培养基上作画
图片尺寸1080x681
生物学霸们用培养基作画
图片尺寸420x397
钱永健实验室用不同颜色标记的细菌在培养基上画的"画".图片:twimg.
图片尺寸1183x1183
我在纸上画画还不行人家已经拿培养基画画啦
图片尺寸530x435
制作材料:大肠杆菌,emp培养基创意描述:马踏飞燕是东汉艺术家的经典之
图片尺寸600x507